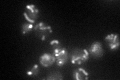

View description
Alpha subunit of succinyl-CoA ligase, which is a mitochondrial enzyme of the TCA cycle that catalyzes the nucleotide-dependent conversion of succinyl-CoA to succinate; phosphorylated
Localization:
Intensity:
Fold change:
Significance:
-
C’ GFP library in SD

mitochondria62.26 -
N' NOP1pr-GFP in SD

mitochondria126.595 -
N' TEF2pr-mCherry in SD

missing0 -
N' NATIVEpr-GFP in SD

missing0 -
N' TEF2pr-VC and Cyto-VN in SD

#N/A0 -
C’ GFP library in SD+DTT

mitochondria94.111.51Yes -
C’ GFP library in SD+H2O2

mitochondria60.30.96No -
C’ GFP library in Starvation Media
mitochondria86.711.39Yes -
C’ GFP library on the background of Pup2-DaMP

mitochondria -
C’ GFP library on the background of CCT mutant

mitochondria67.18511.07898No
